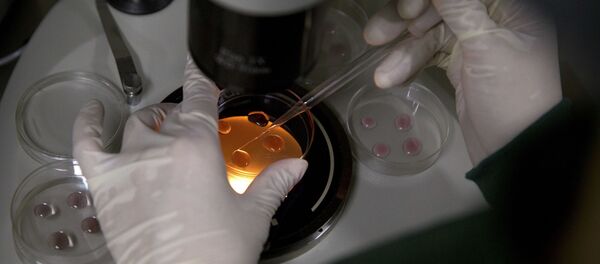
Лабараторија - Sputnik Србија

Од вируса ковид 19 до сада је у свету оболело скоро 2,5 милона људи, док је преминуло скоро 166.000 особа. Све је више је особа које су се опоравиле - више од 636 хиљада.
Највише заражених и преминулих је у САД.
Како је објaвљено на сајту Ворлдометерс, у тој држави инфицирано је 764.265 особа, а преминуло је 40.565. У Шпанији су оболеле 198.674 особе, а преминуло је њих 20.453. Италија има 178.972 инфицирана, док је број смртних случајева 23.660. У Француској је потврђено 152.894 случаја корона вируса, а од инфекције је преминуло 19.718 особа. Немачка има 145.742 случаја, али је број умрлих 4.642, док је у Британији заблежено 120.067 случајева заразе и 16.060 преминулих. Турска се нашла у врху по броју заражених с обзиром да је тај број данас достигао 100 хиљада.
Први пут од почетка пандемије смањио се број заражених у Италији, на дневном нивоу
Први пут од почетка пандемије смањио се број заражених вирусом корона у Италији - не рачунајући особе које су оздравиле и преминуле, број заражених се за дан смањио за 20, изјавио је шеф цивилне заштите Италије Анђело Борели.
„Вирусом корона је тренутно заражено 108.237 особа, што је за 20 мање него јуче. Број заражених се смањио први пут од почетка епидемије“, рекао је Борели.
У Србији још три жртве короне, нових 312 случајева заражених
У Србији су у последња 24 сата још три особе преминуле од последица новог вируса корона, чиме је укупан број умрлих повећан на 125.
Према најновијим подацима објављеним на сајту Министарства здравља, вирус је потврђен код још 312 особа, чиме се број заражених попео на 6.630.
Како се наводи, у последња 24 сата тестирано је 3.111 особа. Излечено је 870 особа.